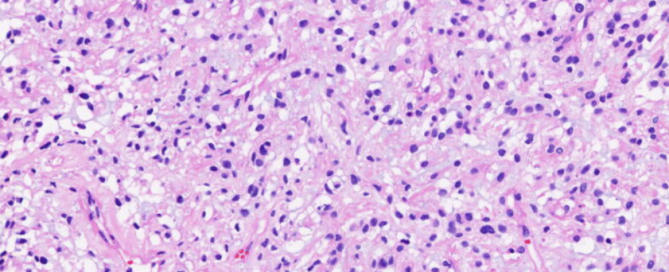
十大滚球体育app

脑膜瘤基因检测助力脑膜瘤患者临床诊疗
脑膜瘤是中枢神经系统常见的肿瘤,根据组织形态将脑膜瘤分为15种亚型。基于组织学的脑膜瘤分级系统难以精准预测肿瘤的生物学行为,为诊治带来一定的挑战。此外,一些脑膜瘤与颅内间叶性肿瘤形态类似,且缺乏特异性诊断标记物,鉴别诊断困难。第5版WHO中枢神经系统肿瘤分类首次将分子特征纳入脑膜瘤分类,使脑膜瘤的诊断、分型及分级更加精确。今天,宁波市临床病理诊断中心葛荣主任医师分享一例诊断和分级困难的脑膜瘤病例,通过阔然基因脑膜瘤分子分型检测和融合基因检测项目对患者检测,辅助患者病理诊断,并进一步为临床治疗提供决策。 病例概况 患者,男,41岁。一月前无明显诱因出现头痛,查头颅MRI提示右侧桥小脑角区占位,脑膜瘤考虑(图1)。行后颅窝肿瘤切除,术后送检组织灰白灰褐色一堆,大小4.5×4.5×0.6cm。组织学:瘤细胞形态一致,卵圆形,间质黏液变(图2)。免疫组化:Vimentin(+++)、EMA(小灶+)、PR(-)、Ki-67(+)5%、P53(-)、GFAP(-)、NSE(-)、Olig2(-)、CgA(-)、Syn(-)、S-100(-)、CD31(-)。病理诊断:(后颅窝肿瘤)脑膜瘤,WHO 1级。术后患者按照WHO 1级脑膜瘤随访。 右侧桥小脑角区可见团块状稍长T1稍长T2信号影,DWI未见明显受限,周围可见脑组织水肿,范围约37mm*22mm*34mm,界尚清,增强呈明显均匀强化,可见脑膜尾征,相应骨质增厚,相应小脑及脑干受压,第四脑室受压。 两年后,患者查头颅MRI提示右侧桥小脑角区脑膜瘤术后,考虑脑膜瘤复发、侵袭可能(图3)。行颅底肿瘤切除,术中肿瘤广泛侵犯乳突骨皮质、硬膜及小脑,延颅底骨质侵犯至颈静脉孔及破裂孔,包绕颈内动脉,肿瘤灰红色,质地韧,血供极其丰富。 术后送检病理,灰白灰红碎组织一堆,总积3×3×1.5cm。组织学:纤维硬化性间质中见多量上皮样小圆细胞浸润,局部间质黏液变(图4),缺乏常见脑膜瘤的形态。免疫组化:MUC-4(弥漫+),CD99(+),Vimentin(+),Fli-1(+),EMA(小灶+),SSTR2(小灶+),PR(-),Desmin(-),CK(pan)(少量+),Syn(灶+),GATA-3(灶+),Ki-67(+3%),,H3K27Me3(+),INI-1(+),CAM5.2(-),PAX-8(-),SOX-10(-),S-100(-),CD31(-),CD34(-),CK5/6(-),GFAP(-),Olig2(-),Calponin(-),SMA(-),STAT6(-),SATB2(-),NKX2.2(-),CD138(-),Wilms Tumor(-)。病理诊断:考虑颅内软组织肿瘤,倾向1.低级别纤维黏液样肉瘤;2.FET-CREB融合阳性的颅内间叶性肿瘤,建议做二代测序分子检测明确。 患者样本通过阔然基因脑膜瘤分子分型检测和融合基因检测项目检测。结果显示,患者肿瘤组织检测出22q缺失、1p、14q缺失(图3)和AP3S2-RWDD2B融合(尚未见文献报道);未检出低级别纤维黏液样肉瘤特异性FUS-CREB3L2融合和颅内间叶性肿瘤FET-CREB家族相关性融合。 根据分子检测结果,患者被确诊为脑膜瘤,分子分型是MC int-A型,同时检出1p/14q染色体缺失,与不良预后和复发风险增加相关,辅助临床解释为何该患者短期复发。 讨论 脑膜瘤是成人最常见的原发性颅内肿瘤,大部分为良性,约20%病例具有侵袭性。组织学分型和分级具有局限性,不能准确反映脑膜瘤的临床预后,因此第5版WHO分类将分子遗传学特征纳入脑膜瘤分类体系中。基于分子检测在脑膜瘤中的研究和应用,阔然基因开发了两款脑膜瘤套餐:脑膜瘤分型用药:针对脑膜瘤相关的基因和部分染色体进行检测,涵盖了脑膜瘤分子分型相关基因、脑肿瘤相关遗传相关基因以及潜在靶向用药相关基因。为脑膜瘤患者的分子分型、靶向用药、预后评估、遗传风险评估及脑胶质瘤发生发展机制提供参考信息,辅助医生制定个体化治疗方案,展示肿瘤突变图谱,促进临床科学研究。 脑膜瘤分子分型检测:利用杂交捕获的方法获得目的基因,并运用二代测序技术检测与脑膜瘤分子分型高度相关的基因的外显子和部分启动子区域。检测信息不仅包括指南推荐与脑膜瘤预后相关基因的变异(点突变、插入、缺失、拷贝数变异)信息,同时还包括了部分染色体变异,为脑膜瘤患者的分子分型、靶向和化疗收益分析、预后评估及脑膜瘤发生发展机制提供参考信息,辅助医生制定个体化治疗方案,展示肿瘤突变图谱,促进临床科学研究和应用。 作者简介 宁波市临床病理诊断中心 主任医师/硕士生导师宁波市临床病理诊断中心神经专科带头人宁波市领军拔尖人才培养对象宁波市卫生健康青年技术骨干人才宁波市医学会外科分会委员,宁波市抗癌协会委员长期从事病理学的医、教、研工作,擅长胶质瘤和脑膜瘤等神经系统疾病的诊断和研究主持和参与省市级科研项目5项,获得专利2项,以第一作者或通信作者发表学术论文30余篇,其中SCI论文7篇